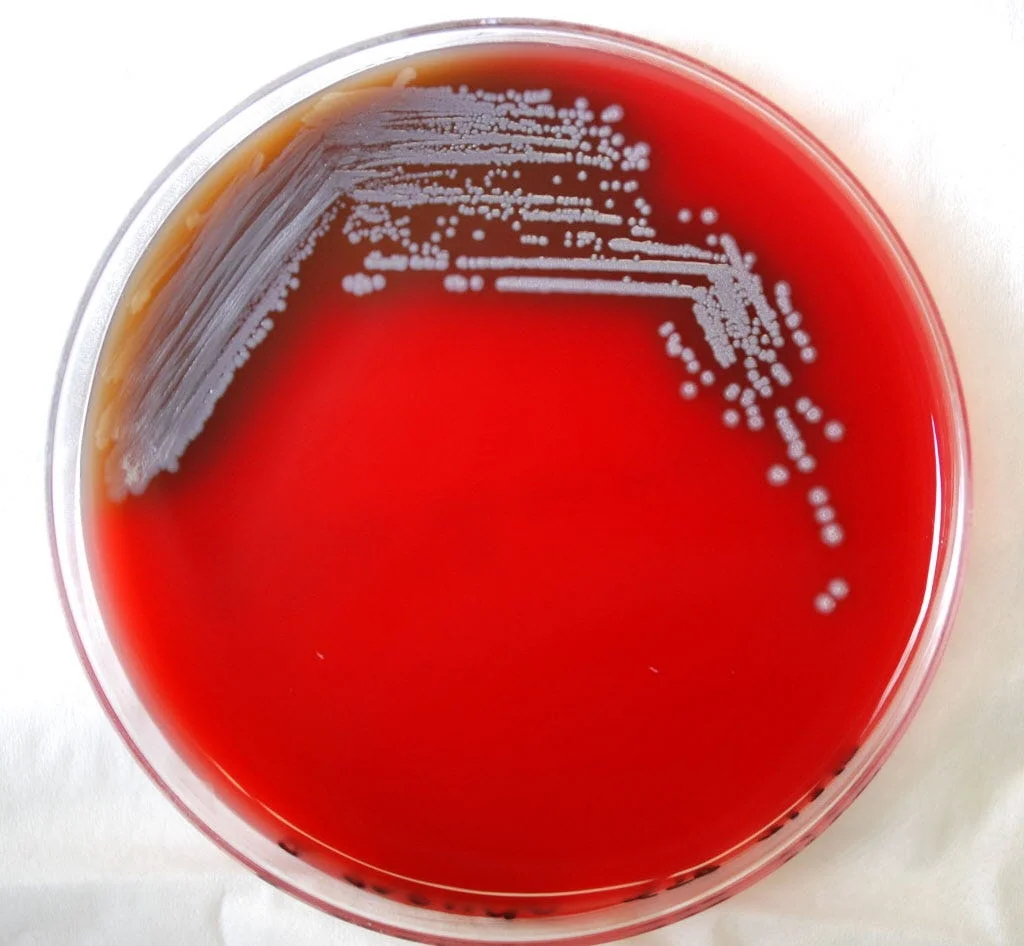
Invasive Bacteria Threatens Southern Gulf States: CDC Warning.

Fish Tank Cleaning Leads to Unexpected Hospital Visit
A 56-year-old woman in Maryland contracted melioidosis, a bacterial infection caused by Burkholderia pseudomallei, after cleaning her fish tank. This case is notable as the woman had not traveled outside the U.S., suggesting the bacteria was present in her aquarium, likely from imported supplies or fish. She required extensive antibiotic treatment to recover. This incident highlights the potential for local cases of melioidosis in the U.S., particularly in regions like the Gulf Coast, where the bacteria has been found in soil and water.